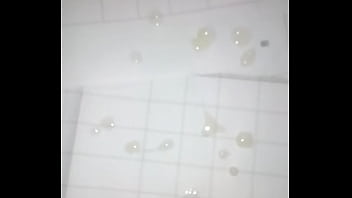
Sunny Lions Photo Cum

Menu
Video Categories
Xvidapi
AI
Amateur
Anal
Arab
Asian Woman
ASMR
Ass
Ass to Mouth
BBW
BDSM
Bi Sexual
Big Ass
Big Cock
Big Tits
Black Woman
Blonde
Blowjob
Brunette
Bukkake
Cam Porn
Creampie
Cuckold
Cumshot
Exotic
Facial
Familial Relations
Feet
Femdom
Fisting
Fucked Up Family
Gangbang
Gapes
Gay
Heels
Indian
Interracial
Japanese
Latina
Lesbian
Lingerie
Massage
Mature
MILF
Oiled
Orgy
Pissing
Pornstar
Real Amateur
Redhead
Sex Dolls
Sex Toys
Sexy
Shaved Pussy
Shemale
Solo Masturbation
Squirting
Stockings
Swingers
Teen
Toons
Unknown
Virtual Reality
Workout